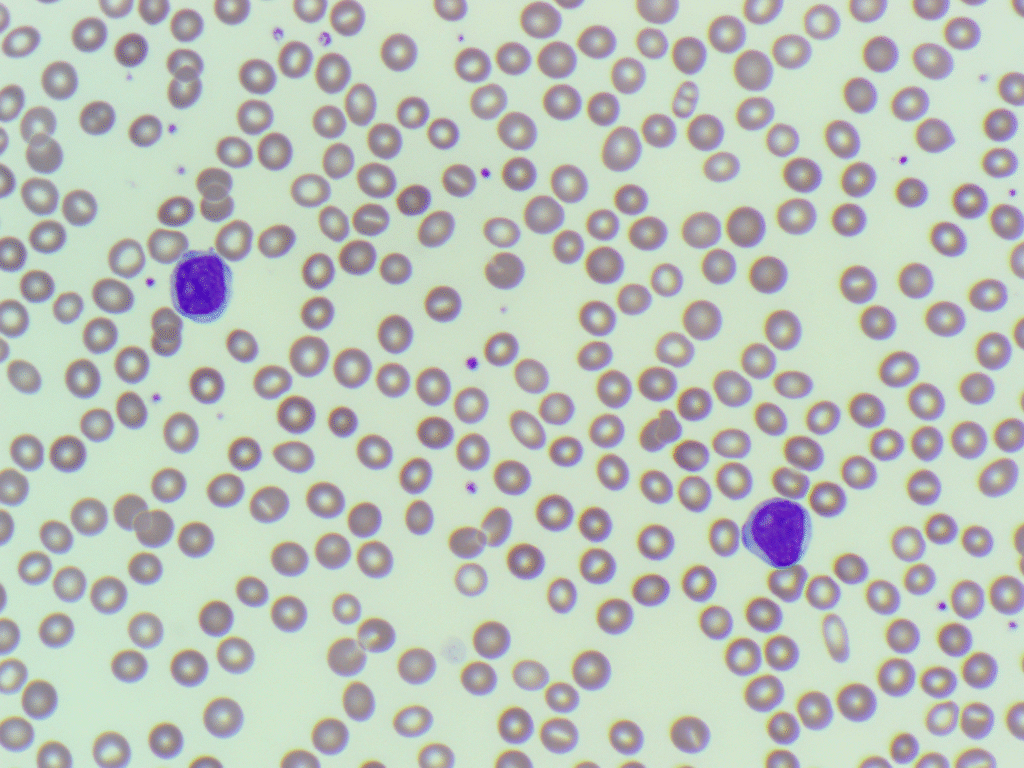
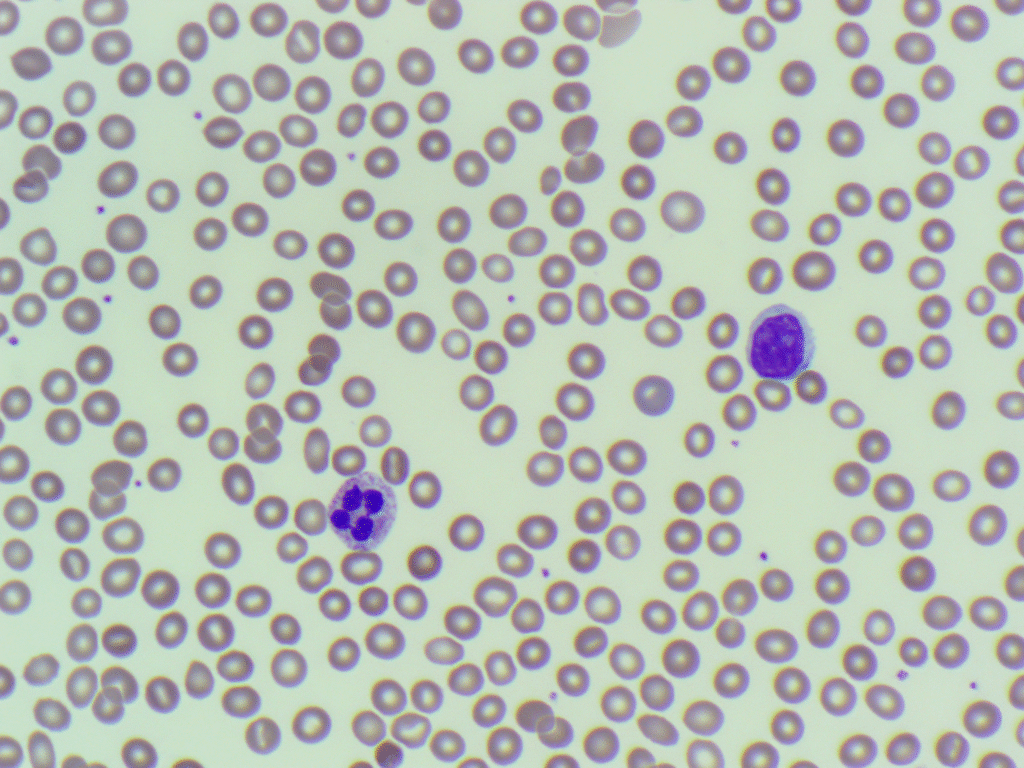
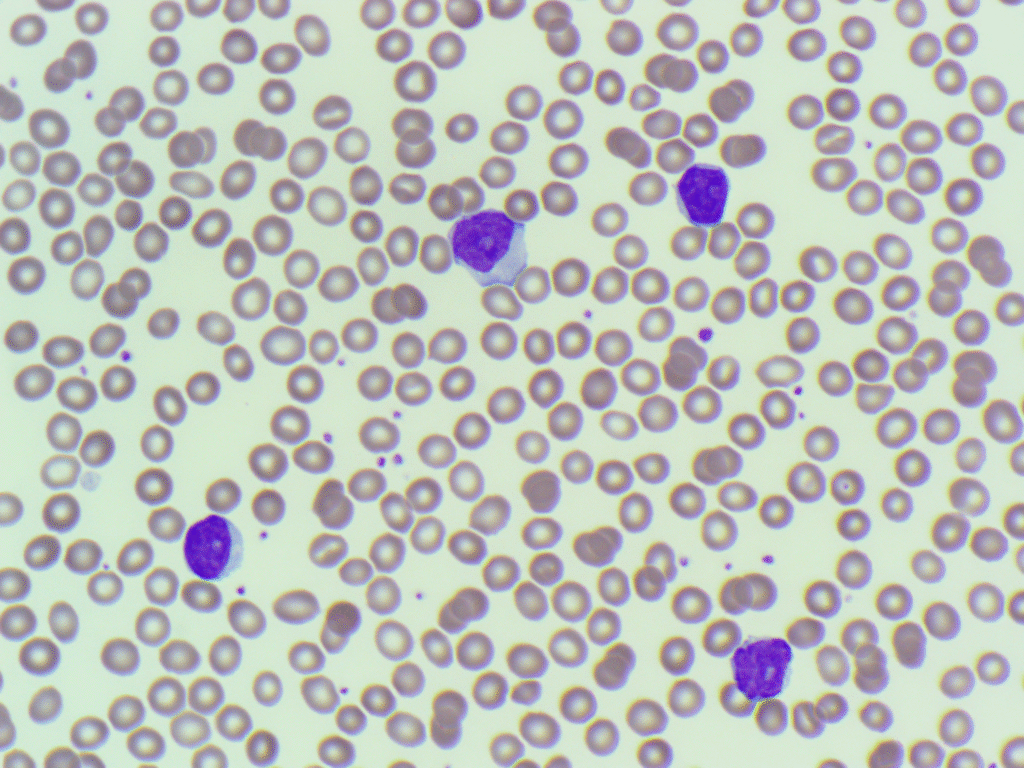
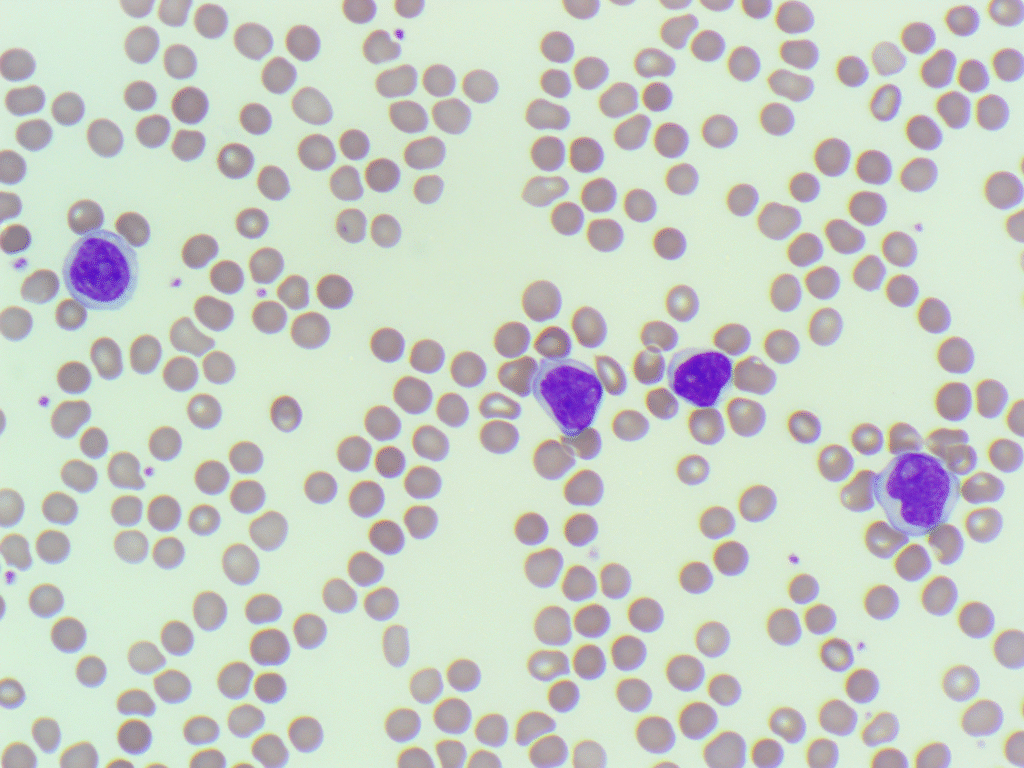

Morphology Monday | Case MM251006
This week’s case comes from a 62-year-old female whose sample was flagged by the analyser, but interestingly, no differential count was produced. The WBC scattergram showed an abnormal grey plot, prompting a manual film review.

Here’s a snapshot of what was seen on the film:

The other laboratory results showed:
- WBC: ~34 ×10⁹/L
- Haemoglobin: 112 g/L
- Platelets: 194 ×10⁹/L
What do you make of this film, and what possibilities come to mind based on these findings and the full blood count?
Privacy Policy | Refund & Return Policy | Only Cells LTD © 2025
